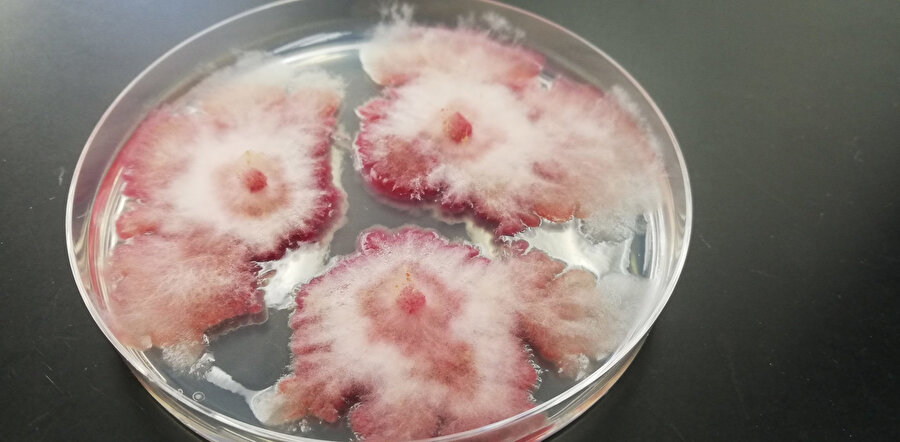
Fusarium graminearum

Çinli araştırmacılar Amerika tarımını bitirecek mi? Fusarium Graminearum mantarı ABD'yi tehdit ediyor

ABD ve Çin arasındaki diplomatik gerilim, 2025'te iki Çinli araştırmacının Fusarium graminearum mantar örneklerini kaçak yolla ülkeye sokma girişimiyle yeni bir boyut kazandı. ABD yetkilileri bunu biyoterörizm olarak değerlendirirken, mantarın tarım ürünlerini yok edebilecek potansiyeli çiftçileri alarma geçirdi.
Bir mantar türü ABD ve Çin arasında biyoterörizm şüphelerini şiddetlendirdi. İki Çinli araştırmacının ülkeye kaçak yollardan soktuğu mantarlar ile ABD'li çiftçilerin rekoltesinin düşürüldüğü iddia edildi.
ABD Adalet Bakanlığı, bu mantarın "potansiyel tarımsal terörizm silahı" olarak sınıflandırıldığını belirterek, araştırmacıları kaçakçılık ve komplo ile suçluyor.
Olaya konu mantar nedir?
Fusarium graminearum, tahıl bitkilerinde (özellikle buğday, arpa, mısır ve pirinç gibi) Fusarium baş yanıklığı (FHB) hastalığına neden olan bir mantar patojenidir.
ABD ve Çin arasındaki sorun, 2025'te iki Çinli araştırmacının mantar örneklerini ABD'ye kaçak yolla sokmaya çalışmasıyla ortaya çıktı.
Araştırmacı Yunqing Jian, mantarı ülkeye kaçak yollardan sokmakla suçlandı. Cezası kapsamında sınır dışı edilecek. Örnekleri bir kitap içinde gizleyerek üniversite laboratuvarına getirdiği ortaya çıktı.
ABD, Çin'i biyoterörizm ile suçluyor. Mantarın adı: Fusarium graminearum.
Özellikle tarladaki buğday, arpa ve mısırların baş kısımlarında yanığa ve döküntüye sebep oluyor.


Bu da ürünlerin rekoltesini ve verimliliğini düşürüyor. Rüzgarlarla uzun mesafelere yayılabildiği için kontrolü çok zor.
Mantarlar dünya genelinde yaygın bir tarım sorunu. ABD'de de sıkça görülüyor ve çiftçiler için önemli bir tehdit.




